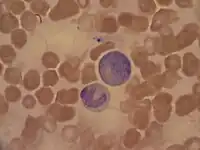

Toxic granulation refers to dark coarse granules found in granulocytes, particularly neutrophils, in patients with inflammatory conditions.[1]
Clinical significance
Along with Döhle bodies and toxic vacuolation, which are two other findings in the cytoplasm of granulocytes, toxic granulation is a peripheral blood film finding suggestive of an inflammatory process.[1] Toxic granulation is often found in patients with bacterial infection and sepsis,[1][2] although the finding is nonspecific.[3] Patients being treated with chemotherapy[3] or granulocyte colony stimulating factor, a cytokine drug, may also exhibit toxic granulation.[2]
Composition
Toxic granules are mainly composed of peroxidase and acid hydrolase enzymes,[3] and are similar in composition to the primary granules found in immature granulocytic cells like promyelocytes.[4][5] Although normal, mature neutrophils do contain some primary granules, the granules are difficult to identify by light microscopy because they lose their dark blue colour as the cells mature. Toxic granulation thus represents abnormal maturation of neutrophils.[6]
Similar conditions
Patients with the inherited condition Alder-Reilly anomaly exhibit very large, darkly staining granules in their neutrophils, which can be confused with toxic granulation.[2][7]
See also
References
- 1 2 3 American Association for Clinical Chemistry (2018-12-09). "Blood Smear". Lab Tests Online. Retrieved 2019-07-30.
- 1 2 3 Barbara J. Bain; Imelda Bates; Mike A Laffan (11 August 2016). "Chapter 5: Blood cell morphology in health and disease". Dacie and Lewis Practical Haematology. Elsevier Health Sciences. p. 93. ISBN 978-0-7020-6925-3.
- 1 2 3 Denise Harmening (2009). "Chapter 5: Evaluation of cell morphology and introduction to platelet and white blood cell morphology". Clinical Hematology and Fundamentals of Hemostasis (5th ed.). F. A. Davis Company. pp. 112–3. ISBN 978-0-8036-1732-2.
- ↑ Anna Porwit; Jeffrey McCullough; Wendy N Erber (27 May 2011). "Abnormalities in leukocyte morphology and number". Blood and Bone Marrow Pathology. Elsevier Health Sciences. p. 255. ISBN 978-0-7020-4535-6.
- ↑ Schofield, K. P.; Stone, P. C. W.; Beddall, A. C.; Stuart, J. (1983). "Quantitative cytochemistry of the toxic granulation blood neutrophil". British Journal of Haematology. 53 (1): 15–22. doi:10.1111/j.1365-2141.1983.tb01981.x. ISSN 0007-1048. PMID 6848117.
- ↑ Eric F. Glassy (1998). Color Atlas of Hematology: An Illustrated Field Guide Based on Proficiency Testing. College of American Patholgists. pp. 40–44. ISBN 978-0-930304-66-9.
- ↑ John P. Greer; Sherrie L. Perkins (December 2008). "Chapter 62: Qualitative disorders of leukocytes". Wintrobe's Clinical Hematology. Vol. 1 (12th ed.). Philadelphia, PA: Lippincott Williams & Wilkins. pp. 1552–3. ISBN 978-0-7817-6507-7.